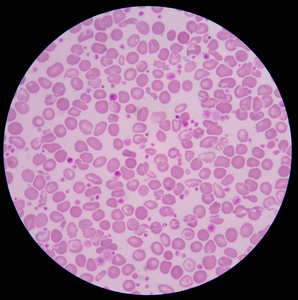
医学背景红血细胞照片

低色素性红细胞

红细胞直径 6μm.正常人偶见,见于低色素性贫血,如缺铁性贫血.
图片尺寸888x664
小细胞低色素性轻度贫血,直接审核掉?
图片尺寸552x738
红细胞低色素症缺铁性贫血
图片尺寸1008x1344
红细胞低色素症缺铁性贫血
图片尺寸1008x1344
红细胞低色素症缺铁性贫血
图片尺寸1008x1344
医学背景红血细胞照片
图片尺寸298x300
血清铁,转铁蛋白饱和度及血清铁蛋白降低为特点的小细胞低色素性贫血
图片尺寸1047x545
这是一个典型的小细胞低色素不均一性Ⅲ期ida.成熟红细胞大小 - 抖音
图片尺寸1920x1440
6fl,网织红细胞 (reticulocyte,ret)11.3%,plt 117×109/l.
图片尺寸523x381
红细胞呈现色素低,细胞小的表现
图片尺寸540x724
医生,这个患儿出现了一个危急值!
图片尺寸341x494
正常红细胞我晓得,家长些又要说莫拽词了,完全听不懂了.
图片尺寸504x329
以致体内储存铁缺乏,影响血红蛋白合成引起的小细胞低色素性贫血
图片尺寸279x251
地贫|红细胞|血常规|血小板|癌症患者_网易订阅
图片尺寸660x615
高倍镜如下可见:红细胞大小不一,体积偏大,可见口形红细胞;淋巴细胞
图片尺寸431x431
患者处于重度贫血状态,根据红细胞相关参数可归类至小细胞低色素性
图片尺寸555x346
比方说,有一类贫血就是红细胞成色不足,术语:低色素性贫血.
图片尺寸954x561
正常红细胞(图片来源网络)
图片尺寸600x600
问:今天上实验课的时候看了一下红细胞.
图片尺寸768x1024
地中海贫血|血红蛋白|胆红素|红细胞|-健康界
图片尺寸662x655